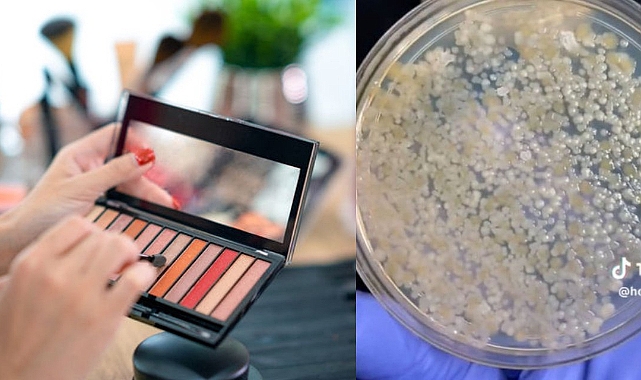

Kozmetik ürünleri satın almadan önce test etmek kulağa iyi bir fikir gibi geliyor olsa da, yeni bir deneyin sonuçları, ürünleri uygulamadan önce iki kez düşünmenizi sağlayacak.İngiliz Daily Mail'de yer alan habere göre, bir TikTok kullanıcısı, rujlar, allıklar, göz farları, kapatıcılar, kalemler ve maskaralardan bakteri barındırıp barındırmadığını görmek için sonuçları rahatsızlık veren sürüntü aldı. Örnekler birkaç gün bekledi, ardından mikrop üreten ürünlerin allıklar, göz farları ve hem dudakta hem de yanakta kullanılabilen renklendiriciler olduğunu paylaştı.Öte yandan diğer ürünlerde stafilokok enfeksiyonları (ciltte ve burun yollarında bulunan bakteriler), idrar yolu enfeksiyonları, solunum yolu hastalıkları ve zatürreye neden olabilen bakteriler ürediğini kaydetti.Uzmanlar ve profesyonel makyaj sanatçıları uzun zamandır, özellikle de 2015 yılında Kaliforniyalı bir kadının tester ruj kullandıktan sonra uçuk çıktığını iddia ederek bir kozmetik markasına dava açmasının ardından, halkı bu tür ortak kullanılan ürünleri kullanmamaya davet etmişti.Ancak yapılan son deneyde o markanın tester rujlarında herhangi bir bakteriye rastlanmadığı iddia edildi.Ruj, kapatıcı ve maskara örneklerinin tamamen temiz çıktığı, ancak bakteri içeren diğer grubun mikroplarla dolu olduğunu paylaştı. Enfekte olmuş kaplarda yüzlerce küçük nokta ve kullanılmış makyaj malzemelerinin üzerinde lekeler vardı.Test edilecek makyaj malzemelerinin kullanılabilmesi için tüketicilere pedler ve diğer aparatlar sağlanıyor; ancak birçok kişi bunun yerine parmaklarını kullanmayı tercih ediyor ya da makyaj malzemelerini doğrudan yüzlerine uyguluyor.Londralı bir influencer olan Amira Saskia, 2022 yılında tester ürünleri kullandığını gösteren videolarla manşetlere çıkmıştı. 18 yaşındaki genç kızın makyaj malzemelerini ve fırçaları doğrudan yüzüne uyguladığı görülmüştü.
Yaşam Tarzı ve Sağlık
Yayınlanma: 26 Mayıs 2023 - 13:52
O deney kozmetik ürünlerindeki bakterileri ortaya çıkardı! Sakın kullanmayın...
Bir TikTok kullanıcısı, yaptığı deneyle ortak kullanılan kozmetik ürünlerinin bakterilerle dolu olduğunu ortaya çıkardı. Rujlar, maskaralar ve kapatıcıların temiz olduğu iddia edilirken; allıklar, göz farları ve hem dudakta hem de yanakta kullanılabilen renklendiricilerin bakteri dolu olduğu gözler önüne serildi.
Yaşam Tarzı ve Sağlık
26 Mayıs 2023 - 13:52